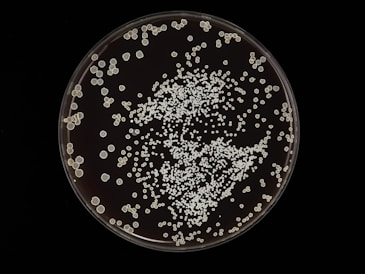
a plate filled with lots of white stuff
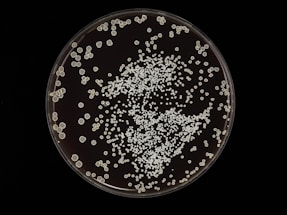
a plate filled with lots of white stuff

TURNKEY & OPERATIONAL SOLUTIONS
Dialysis expansion rarely fails at the planning stage. It fails when operations meet reality.
SHK Medical works with dialysis operators, distributors, and healthcare investors to design, stabilise, and operate dialysis systems in Africa, the Middle East, and the Caribbean — where cost, continuity, and compliance are inseparable.
This is operator-level execution support grounded in lived operational responsibility.
Pre-Expansion Structural Review
Before facilities are built or manufacturing systems are commissioned, structural alignment must be assessed.
For investors and operators committing capital into dialysis infrastructure in emerging markets, we provide focused pre-expansion reviews covering:
Capital allocation and lifecycle modelling
Procurement architecture and supplier resilience
Local production feasibility and regulatory integration
Operational control frameworks before launch
This work is selective and typically precedes turnkey or operational execution projects.
Where expansion risk is high, clarity should come before commitment.


Turnkey Dialysis Facilities
We plan, build, and commission dialysis centres with full operational context — not just equipment lists.
This includes:
Dialysis layout and workflow design
Equipment selection (HD machines, chairs, water treatment)
Supply chain integration from day one
Staff readiness and operational handover
Built for reliability, not ideal conditions.
We design and deliver dialysis operations that hold under pressure.
Local Production & Concentrate Manufacturing
Where import dependency drives cost and systemic risk, we design local production systems.
This includes:
Dialysis concentrate mixing plants
Bottling, filling, and quality control systems
Regulatory alignment and compliance support
Training and operational ramp-up
The goal isn’t localisation for optics.
It’s control, resilience, and cost stability.


Operational Stabilisation & Control
For existing clinics or networks under strain.
We help operators:
Identify where control has been lost between HQ and local execution
Correct distributor or partner misalignment
Rebuild visibility across supply, inventory, and delivery
Reduce emergency procurement and firefighting
This work often starts when things “look fine” — but feel wrong.
Infection Control & Clinical Operations Support
In dialysis, infection risk isn’t theoretical.
It’s operational.
We provide:
Practical infection management training
Dialysis-specific protocols grounded in real clinics
Compliance and quality assurance support
Ongoing staff education
Safer operations protect patients — and protect the business

HOW THIS WORK IS DIFFERENT
Most projects focus on:
Strategy decks
Market sizing
Best-practice assumptions
Our work focuses on:
What actually breaks first
Where cost escalates quietly
How continuity fails
Which risks are structural and which are operational
WHY SHK MEDICAL
SHK Medical isn’t approaching this from the outside.
We have:
Built and operated dialysis-related businesses across multiple regions
Designed supply chains under currency, regulatory, and logistics pressure
Managed environments where delays affect patient care — not just margins
That experience shapes how we work:
Calm. Direct. Execution-first.
ENGAGEMENT MODEL
Every engagement is bespoke — because every market behaves differently.
Work may include:
Short diagnostic engagements
Project-based execution
Ongoing operational support
We are selective about projects — because reliability depends on focus.



If you’re planning a dialysis project — or operating one that feels heavier than it should — the issue is rarely ambition.
It’s usually structure, control, or assumptions that no longer fit reality.
If you want to build — or stabilise — a dialysis operation that works under real-world pressure, let’s talk.
